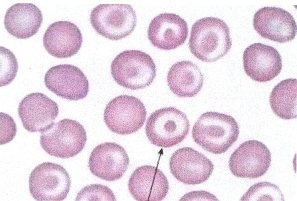
c72e5739e85cda90f39ee3dddc320a06.png

高频考题
1、以下属于尿量不增加的情况是
A、尿崩症B、糖尿病
C、利用利尿剂
D、大量饮水
E、交感神经兴奋
【答案】E
【解析】引起多尿的情况有:饮水过多或食用含水分高的食物,服用有利尿作用的食品、使用某些药物,尿崩症,糖尿病。故选E。综上所述,本题正确答案选E:交感神经兴奋;
因为交感神经兴奋通常不是引起尿量增加的主要生理或病理原因。
2、不属于必须微量元素的是
A、锌B、碘
C、铁
D、硒
E、铅
【答案】E
【解析】本题答案选:E:铅;
属于必需的微量元素有铁、锌、铜、锰、铬、钳、钴、硒、镍、钒、锡、氟、碘、硅等,再加上非必需的微量元素共有数十种。有些元素,如铋、锑、镉、汞、铅等对人体有害
3、外周血涂片镜检,如图示,箭头所示的细胞是
A、椭圆形红细胞
B、巨大红细胞
C、靶形红细胞
D、口形红细胞
E、镰形红细胞
【答案】C
【解析】靶形红细胞:细胞中央染色较深,外围为苍白区域,而边缘又深染,形如射击之靶。有时,中央深染区呈细胞边缘延伸的半岛状或柄状。细胞直径比正常大,但厚度变薄。
4、细菌的芽孢受外界环境条件影响可发生变异,此变异属于
A、形态和结构变异B、培养特性变异
C、毒力变异
D、耐药性变异
E、酶活性变异
【答案】A
【解析】形态与结构变异:细菌在不同的生长时期菌体形态和大小可以不同,生长过程中受外界环境条件的影响也可发生形态变异。细菌的一些特殊结构,如荚膜、芽孢、鞭毛等也可发生变异。
5、心脏特异性肌钙蛋白通常是指
A、cTnI和cTnTB、CK
C、Mb
D、AST
E、TnC
【答案】A
【解析】目前,用于ACS实验室诊断的是cTnT和cTnI。
6、血小板聚集试验主要用于
A、P选择素B、GPV
C、血小板GPⅠb-Ⅸ复合物的活性
D、血小板GPⅡb/Ⅲa活性
E、血小板的释放功能
【答案】D
【解析】血小板聚集试验主要用于评估血小板GPⅡb/Ⅲa活性。
这一机制下,在Ca²⁺的存在条件下,活化的血小板通过GPⅡb/Ⅲa复合物与纤维蛋白原结合,从而发生聚集。
因此,正确答案为D:血小板GPⅡb/Ⅲa活性。
7、不属于成分输血优点的是
A、可提高疗效B、血液使用更合理
C、避免输血传播疾病
D、减少反应
E、可节省血源
【答案】C
【解析】避免输血传播疾病的选项不属于成分输血的主要优点。
成分输血的优点为:疗效高、反应少、合理用血液成分、经济。
8、弥散性血管内凝血的病因最多见的是
A、烧伤B、白血病
C、病理产科
D、免疫性疾病
E、感染性疾病
【答案】E
【解析】DIC常发生于严重感染(败血症、重症肝炎)、严重创伤(挤压伤、体外循环)、广泛性手术(扩大根治术、大面积烧伤)、恶性肿瘤(广泛转移、急性早幼粒细胞白血病)、产科意外(羊水栓塞、胎盘早剥)以及其他疾病等。
9、肺炎链球菌可引起的疾病是
A、支气管肺炎B、肺脓肿
C、大叶性肺炎
D、支气管哮喘
E、胸膜炎
【答案】C
【解析】肺炎链球菌主要引起的大叶性肺炎。
10、阴道毛滴虫的感染方式是
A、经口B、直接经皮肤
C、直接接触或者间接接触
D、经胎盘
E、经媒介昆虫叮咬
【答案】C
【解析】阴道毛滴虫主要通过直接接触或间接接触的方式进行传播。
直接接触指的是与感染者有性行为时,通过生殖器间的直接接触传播;
间接接触则可能包括使用了被感染者的个人卫生用品,如毛巾、浴盆等。
因此,正确答案是 C: 直接接触或者间接接触。
11、不属于糖尿病的诊断标准是
A、随机糖≥11.1mmol/LB、多食、多饮、多尿、体重减轻
C、胰岛素含量
D、口服葡萄糖耐量试验≥11.1mmol/L
E、空腹血糖≥7.0mmol/L
【答案】C
【解析】糖尿病的诊断标准主要依据以下几个方面:
1. 糖尿病症状 + 随机静脉血浆葡萄糖浓度 ≥ 11.1 mmol/L 或者 空腹静脉血浆葡萄糖浓度 ≥ 7.0 mmol/L;
2. 口服葡萄糖耐量试验 (OGTT) 中 2小时静脉血浆葡萄糖浓度 ≥ 11.1 mmol/L;
3. HbA1c 浓度 ≥ 6.5%。
其中,“胰岛素含量”并不是糖尿病的诊断标准。
胰岛素水平可能在糖尿病患者中有所变化,但它不是用于诊断糖尿病的直接指标。
诊断糖尿病时,通常关注的是血糖水平,而非胰岛素含量。
因此,正确答案是 C: 胰岛素含量。
12、下列关于血沉测定的叙述,错误的是
A、妇女月经期血沉可略增快B、随年龄增加,血沉减慢
C、炎症时可见血沉增快
D、常用于观察结核病有无活动性及其动态变化
E、手术创伤可导致血沉增快
【答案】B
【解析】血沉测定结果并非随年龄增加而普遍减慢。
实际上,老年人由于生理原因,血沉可能会出现生理性增快。
因此,选项B“随年龄增加,血沉减慢”是错误的表述。
13、血浆T3和T4含量增加时可反馈抑制
A、ACTH分泌B、FSH分泌
C、LH分泌
D、PRL分泌
E、TSH分泌
【答案】E
【解析】血浆T3和T4含量增加时,会通过负反馈机制抑制下丘脑释放促甲状腺激素释放激素(TRH),进而抑制垂体分泌促甲状腺激素(TSH)。
因此,正确答案是E:TSH分泌。
14、成人男性血红蛋白正常参考值为
A、100~140g/LB、140~170g/L
C、110~150g/L
D、170~200g/L
E、120~170g/L
【答案】E
【解析】血红蛋白正常参考值范围:
1.成年:男性为120~170g/L;女性为110~150g/L。
2.新生儿:170~200g/L。
3.老年(70岁以上):男性为94.2~122.2g/L;女性为86.5~111.8g/L。
15、白喉棒状杆菌的致病物质是
A、内毒素B、白喉外毒素
C、制热毒素
D、类毒素
E、抗毒素
【答案】B
【解析】白喉棒状杆菌的致病物质是白喉外毒素。
16、唯一能降低血糖的激素是
A、胰岛素B、肾上腺素
C、生长素
D、甲状腺素
E、高血糖素
【答案】A
【解析】唯一能降低血糖的激素是胰岛素。参与血糖浓度调节的激素有两类:一类是降低血糖的激素,主要有胰岛素和胰岛素样生长因子;一类是升高血糖的激素,这类激素包括肾上腺素、胰高血糖素、肾上腺皮质激素和生长激素等。
17、机体对低血糖最为敏感的组织器官是
A、肝脏B、心脏
C、大脑
D、肌肉
E、肺
【答案】C
【解析】大脑对低血糖最为敏感,因为它依赖于血糖作为几乎唯一能量来源,且无糖原储备以维持能量供应。
18、脑膜炎奈瑟菌传播的主要方式是
A、由动物传染人B、借飞沫经空气传播
C、粪-口传播
D、昆虫传播
E、输血传播
【答案】B
【解析】脑膜炎奈瑟菌主要通过借飞沫经空气传播的方式在人群中传播,特别是在冬末春初的季节,这种疾病的流行高峰尤为明显。
因此,正确答案是B:借飞沫经空气传播。
19、患儿男,5岁。发热4天就诊,白细胞计数23.2×109/L,中性粒细胞占80%,伴核左移,可见明显毒性颗粒、核固缩。增多的中性粒细胞主要反映下列哪个池中的数量
A、分裂池B、成熟池
C、贮备池
D、循环池
E、边缘池
【答案】C
【解析】增多的中性粒细胞主要反映的是“贮备池”的数量变化。
在面对感染或应激反应时,骨髓中的成熟粒细胞会从“贮备池”释放到血液循环中,以应对身体的需求。
20、下列哪项不是引起红细胞相对增多的原因
A、严重腹泻B、多尿
C、大面积烧伤
D、多汗
E、某些先天性心脏病
【答案】E
【解析】(1)原发性红细胞增多:如真性红细胞增多症、良性家族性红细胞增多症等。
(2)继发性红细胞增多:如房室间隔缺损、法洛四联症等各种先天性心血管疾病;肺气肿、肺源性心脏病、肺纤维化、硅肺和各种引起肺气体交换面积减少的疾病;异常血红蛋白病;肾上腺皮质功能亢进(库欣综合征);某些药物影响如肾上腺素、糖皮质激素、雄激素等。
(3)相对性红细胞增多:如呕吐、严重腹泻、多汗、多尿、大面积烧伤、晚期消化道肿瘤而长期不能进食等。
21、正常情况下,不存在于血液中的凝血因子是
A、凝血因子ⅧB、凝血因子Ⅶ
C、凝血因子Ⅲ
D、凝血因子Ⅸ
E、凝血因子Ⅰ
【答案】C
【解析】凝血因子目前包括14个,除FIII存在于全身组织中,其余均存在于血浆中。
22、内源性凝血途径的始动因子是
A、凝血因子Ⅳ被激活B、凝血因子FⅫ被激活
C、血小板破裂
D、凝血酶的形成
E、因子Ⅸ被激活
【答案】B
【解析】内源凝血途径:内源凝血途径是指由FⅫ被激活到FⅨa-Ⅷa-Ca2+-PF3复合物形成的过程。故选B。
23、新型隐球菌的主要传播方式是
A、病人一咯痰一飞沫传播B、鸽子一粪便一呼吸道传播
C、病人一粪便一消化道传播
D、病人一粪便一呼吸道传播
E、人虱一类便一破损皮肤传播
【答案】B
【解析】新型隐球菌的主要传播方式是通过鸽子的粪便,经呼吸道吸入。
这种传播途径使得隐球菌能够从外部环境进入人体,特别是通过呼吸系统,引发感染。
24、患者,女,22岁。出现泌尿系感染症状,但常规尿细菌培养为阴性。要进行尿液厌氧菌培养,应如何采集标本
A、留取清洁中段尿B、耻骨联合上膀胱穿刺
C、留取初段尿液
D、釆用导尿管导尿
E、留取末端尿
【答案】B
【解析】尿液标本,疑为厌氧菌感染时,应以无菌注射器从耻骨上缘行膀胱穿刺术抽取;若怀疑是需氧或兼性厌氧菌的感染,则可通过自然导尿获取标本。因此,正确答案是B:耻骨联合上膀胱穿刺。
25、Ph染色体常见于
A、急性粒细胞白血病B、慢性粒细胞白血病
C、急性单核细胞白血病
D、慢性淋巴细胞白血病
E、急性早幼粒细胞白血病
【答案】B
【解析】Ph染色体是慢性粒细胞白血病的特异性异常染色体,检出率为90%~95%。
26、口服抗凝剂的监测指标是
A、CTB、RT
C、PT
D、ACT
E、APTT
【答案】C
【解析】口服抗凝剂的监测指标是PT(部分凝血活酶时间)。
PT:它是监测口服抗凝剂的首选指标。据报道,在应用口服抗凝剂化过程中,使PT维持在正常对照值[(12.0±1.0)s]的1.5~2.0倍,使凝血酶原时间比率(prothrombin time ratio,PTR)维持在1.5~2.0为佳。
27、成年女性魏氏法测定血沉的参考值为
A、0~5mm/hB、5~15mm/h
C、0~20mm/h
D、0~15mm/h
E、3~15mm/h
【答案】C
【解析】成年女性魏氏法测定血沉的参考值为0~20mm/h。
28、出生后正常情况下人体最大的造血器官是
A、脾脏B、肝脏
C、骨髓
D、胸腺
E、淋巴结
【答案】C
【解析】骨髓造血:出生后在正常情况下,骨髓是唯一产生红细胞、粒细胞和血小板的场所,也产生淋巴细胞和单核细胞。
29、阴道分泌物中常见的细胞是
A、柱状上皮细胞B、鳞状上皮细胞
C、红细胞
D、白细胞
E、线索细胞
【答案】B
【解析】阴道分泌物中常见的细胞是鳞状上皮细胞(选项B)。
阴道脱落细胞多数为宫颈及阴道上皮,较少见子宫内膜细胞。阴道细胞学检查在脱落细胞中应用最为广泛。从外阴向内直至子宫颈外口的黏膜均被覆鳞状上皮。
30、造血微环境不包括
A、基质B、网状细胞
C、间充质干细胞
D、末梢神经
E、微血管系统
【答案】C
【解析】选项C:“间充质干细胞”不属于造血微环境的组成部分。
造血微环境是指造血器官实质细胞四周的支架细胞、组织。它包括微血管系统、末梢神经、网状细胞、基质以及基质细胞分泌的细胞因子。
31、目前用于HRP标记抗体或抗原的最常用方法是
A、戊二醛交联一步法B、戊二醛交联二步法
C、直接法
D、间接法
E、改良过碘酸钠法
【答案】E
【解析】改良过碘酸钠法是目前应用最广泛的HRP标记抗体或抗原的方法。
32、组成成人HbA的珠蛋白肽链是
A、α2β2B、α2γ2
C、α2δ2
D、α2ζ2
E、ζ2ε2
【答案】A
【解析】组成成人HbA的珠蛋白肽链是α2β2。
这一组合反映了在人类生长发育过程中血红蛋白类型的转变,特别是在胎儿期和新生儿期,随着不同珠蛋白链(α、β、γ、δ、ζ和ε)的合成,形成了不同类型的血红蛋白。
到成人阶段,α和β链的组合占主导地位,形成HbA,这是成人血红蛋白的主要形式。
33、血液的pH约为
A、7.35~7.45B、7.10~7.20
C、7.30~7.40
D、7.45~7.55
E、6.90~7.15
【答案】A
【解析】正常人血液的pH值约为7.35~7.45。
这一数值反映了血液的酸碱平衡状态,是维持生命活动的重要生理指标之一。
34、血友病A出现
A、FIB升高B、FIB减低
C、FⅧ减低
D、FⅦ减低
E、FⅩⅢ减低
【答案】C
【解析】血友病A主要特征是因子Ⅷ(FⅧ)水平减低,导致凝血功能异常,引起出血倾向。
因此,正确答案为 C: FⅧ减低。
35、脂蛋白电泳时向正极迁移速度最快的是
A、CMB、VLDL
C、LDL
D、IDL
E、HDL
【答案】E
【解析】脂蛋白电泳时,向正极迁移速度最快的脂蛋白是高密度脂蛋白(HDL)。
其迁移速度快的原因在于HDL的分子最小,所带净电荷量也最多,因此在电场作用下能够快速移动。
36、下列可引起中性粒细胞减少的疾病是
A、脾功能亢进B、急性心肌梗死后1~2天
C、急性溶血
D、肺吸虫病
E、急性细菌性肺炎
【答案】A
【解析】脾功能亢进会导致中性粒细胞减少。中性粒细胞减低见于:①感染:如伤寒、副伤寒、流感等;
②血液病:如典型的再生障碍性贫血、少数急性白血病;
③理化损伤:如电离辐射(X线等)、长期服用氯霉素后;
④免疫性疾病:如系统性红斑狼疮(SLE)等;
⑤脾功能亢进:如门脉性肝硬化、班替综合征等。
37、HRP的底物中最常用的是
A、TMBB、OPD
C、ABTS
D、5-ASA
E、4MUG
【答案】A
【解析】TMB是一种优于OPD的新型HRP色原底物。已成为目前ELISA中应用最广泛的底物。缺点是水溶性差。
尽管水溶性较差是其唯一的缺点,但这一特性并未显著影响其在ELISA中的广泛应用。
因此,当面临选择HRP底物时,TMB通常成为首选。
38、可通过胎盘引起新生儿溶血病的孕妇血型抗体属于
A、IgGB、IgM
C、IgA
D、IgD
E、IgE
【答案】A
【解析】通过胎盘引起新生儿溶血病的孕妇血型抗体属于IgG类抗体。
39、与甲状腺功能亢进无关的表现是
A、肠蠕动减慢B、神经兴奋性升高
C、心率加快
D、基础代谢率明显升高
E、甲状腺肿大
【答案】A
【解析】选项A:“肠蠕动减慢”与甲状腺功能亢进无关。
甲状腺功能亢进时,由于代谢率增加,通常伴随消化系统活动的增强,包括肠蠕动的加速,而不是减慢。
因此,肠蠕动减慢不是甲状腺功能亢进的表现。
40、血浆钾离子浓度会降低的情况是
A、创伤B、高烧
C、严重腹泻
D、饱餐后
E、缺氧
【答案】C
【解析】钾丢失或排出增多:常见于严重腹泻、呕吐、胃肠减压和肠瘘者。会导致低钾血症。
41、引起传染性单核细胞增多症的病毒是
A、EB病毒B、HPV病毒
C、HSV病毒
D、狂犬病毒
E、乙肝病毒
【答案】A
【解析】传染性单核细胞增多症(IM),是由EB病毒(EBV)引起的一种急性或亚急性淋巴细胞良性增生的传染病。
42、诊断细菌性阴道病的重要指标是
A、脂肪细胞B、线索细胞
C、泡沫细胞
D、巨噬细胞
E、汗腺细胞
【答案】B
【解析】诊断性细菌性阴道病的重要指标是线索细胞。
细菌性阴道炎的临床诊断依据为:
(1)线索细胞:为阴道鳞状上皮细胞黏附大量加德纳菌及其他短小杆菌后形成。
(2)PH>4.5。
(3)胺试验:阳性。
(4)阴道分泌物稀薄均匀。
凡有线索细胞,再加上述任意其他2条,诊断即成立。
43、霍奇金病与非霍奇金淋巴瘤的鉴别,最重要的是
A、发病年龄B、淋巴结首发部位
C、并发白血病
D、R-S细胞
E、白蛋白降低
【答案】D
【解析】CHL的组织学共同特征是少量的霍奇金细胞(单核)或Reed-Sternberg细胞(多核)散布于大量的反应性背景细胞中,它们包括淋巴细胞、嗜酸性粒细胞、浆细胞和组织细胞及不等量胶原纤维。霍奇金病的骨髓象多为非特异性改变。若骨髓穿刺涂片检查找到R-S细胞对诊断有重要意义。
44、传染性单核细胞增多症,可见的异常细胞是
A、镜影细胞B、异型淋巴细胞
C、单核细胞
D、中性粒细胞
E、嗜酸性粒细胞
【答案】B
【解析】传染性单核细胞增多症时,异常可见的细胞类型是异型淋巴细胞。
这类细胞在病毒性感染或变应原刺激下,淋巴细胞增生并出现形态学变化形成。
异型淋巴细胞存在多种形态,包括空泡型、不规则型以及幼稚型,其特征在于细胞体积增大、核形态多样、染色质分布不均以及胞质颜色和结构的变化。
这些特征有助于在血液检查中识别传染性单核细胞增多症的患者。
45、白血病MICM分型依据不包括
A、形态学B、免疫学
C、细胞生物学
D、细胞遗传学
E、分子生物学
【答案】C
【解析】随着免疫学和细胞遗传学的发展,国际上在白血病FAB分型的基础上,结合其形态学、免疫学和细胞遗传学特征,提出了白血病MIC分型。分子生物学技术的崛起与发展,人类基因组的破译,使其对染色体易位形成融合基因的检出更能反映急性白血病的生物学本质,从而提出了白血病的MICM分型方案。
46、人体中主要调节机体酸碱平衡的是
A、HCO3-B、K+
C、Na+
D、Ca2+
E、Cu2+
【答案】A
【解析】人体中主要调节机体酸碱平衡的是HCO3-。
这是因为细胞外液的主要阴离子以Cl-和HCO3-为主,它们在维持酸碱平衡方面发挥关键作用。
47、红细胞直方图中出现双峰多见于
A、珠蛋白生成障碍性贫血B、缺铁性贫血恢复期
C、慢性疾病贫血
D、再生障碍性贫血
E、难治性贫血
【答案】B
【解析】红细胞直方图中出现双峰,特别是在小细胞峰明显左移的情况下,多见于缺铁性贫血在治疗后的恢复阶段。
这是因为缺铁性贫血在得到铁补充后,红细胞的合成和成熟过程得以改善,小细胞(低色素)红细胞的比例减少,同时大细胞(正常或高色素)红细胞的数量增加,导致直方图上形成两个明显的峰。
这种现象反映了红细胞大小和色素含量的不均一性恢复的过程。
48、关于钙代谢,叙述正确的是
A、在胃吸收B、被动吸收
C、偏酸时吸收减少
D、食物中的草酸促进吸收
E、活性维生素D3促进吸收
【答案】E
【解析】关于钙的代谢,正确的是活性维生素D3促进其吸收。
钙在十二指肠吸收,是在活性维生素D3调节下的主动吸收,肠管的pH可明显的影响钙的吸收,偏碱时减少钙的吸收,偏酸时促进吸收。
49、成年男性红细胞计数参考值
A、(4.0~5.5)×1012/LB、(4.2~5.2)×1012/L
C、(3.5~5.0)×1012/L
D、(6.0~7.0)×1012/L
E、(5.0~6.0)×1012/L
【答案】A
【解析】红细胞参考值:成年男性(4.0~5.5)×1012/L;成年女性(3.5~5.0)×1012/L;新生儿(6.0~7.0)×1012/L。
50、药物通过肾小球排泄的主要方式是
A、主动转运B、被动扩散
C、滤过
D、易化扩散
E、胞饮
【答案】C
【解析】药物通过肾小球排泄的主要方式是滤过。
51、患者女,22岁,月经过多,乏力,易倦,气促,面色苍白,Hb98g/L,MCV65fl,血清铁7.0μmol/L,经铁剂治疗一周,效果良好,此时,最具特征性的实验室改变是
A、网织红细胞计数B、嗜酸性粒细胞计数
C、红细胞沉降率
D、白细胞计数
E、红细胞计数
【答案】A
【解析】网织红细胞计数可观察贫血疗效,缺铁性贫血、巨幼细胞贫血患者治疗前,网织红细胞仅轻度增高(也可正常或减少),给予铁剂或维生素B12、叶酸治疗3~5d后,网织红细胞开始上升,7~10d达高峰,2周后网织红细胞逐渐下降至正常水平,表明治疗有效。故选A。因此,正确答案是:A:网织红细胞计数
52、患者女,25岁。停经40天,腹痛待查,应首先留尿检测
A、红细胞B、白细胞
C、尿蛋白
D、尿hCG
E、酮体
【答案】D
【解析】该患者停经40天,怀疑早期妊娠,检测尿中hCG含量。一般妊娠后35~40d时,hCG为200ng/L以上。因此,正确的选择是D:尿hCG。
其他选项如红细胞、白细胞、尿蛋白和酮体与当前情况关联性较低,不是首选检测项目。
53、下列哪项不是引起肾小管性蛋白尿的常见病因
A、间质性肾炎B、急性肾炎
C、药物中毒
D、急性肾盂肾炎
E、重金属中毒
【答案】B
【解析】本题考查肾小管性蛋白尿的常见病因。
选项中,急性肾炎是引起肾小球性蛋白尿的常见病,而非肾小管性蛋白尿。
因此,正确答案是 B: 急性肾炎。
肾小管性蛋白尿通常与肾小管间质病变、重金属中毒、药物中毒、器官移植等有关。
而急性肾炎主要导致的是肾小球性蛋白尿,而不是肾小管性蛋白尿。
54、关于免疫组织化学技术中组织标本处理的叙述,不正确的是
A、可立即做冰冻切片处理B、可立即用固定液脱水后行石蜡切片
C、检测材料及时处理
D、防止组织块干燥
E、可在普通冰箱中保存2天以上
【答案】E
【解析】关于免疫组织化学技术中组织标本处理的叙述,正确的做法包括立即进行冰冻切片处理、立即使用固定液脱水后进行石蜡切片、确保检测材料及时处理以及防止组织块干燥。
然而,将组织标本在普通冰箱中保存超过2天以上并不推荐,因为这可能影响后续免疫组织化学实验的效果。
因此,正确答案为“可在普通冰箱中保存2天以上”。
55、衰老红细胞的破坏主要在
A、肝脏B、脾脏
C、骨髓
D、肺
E、肾脏
【答案】B
【解析】红细胞平均寿命约120d,衰老红细胞主要在脾破坏,分解为铁、珠蛋白和胆红素。
56、患者女,40岁。近来出现体重增加及向心性肥胖,四肢肌肉萎缩,腹部有紫斑,多毛。实验室检查:血糖增高,葡萄糖耐量减低,血红细胞增高,白细胞总数及中性粒细胞增高,血Na+增高,K+、Ca2+降低,临床诊断可考虑为
A、嗜络细胞瘤B、Addis病
C、肾上腺皮质功能亢进
D、甲状腺功能亢进
E、泌乳素瘤
【答案】C
【解析】患者的表现包括体重增加、向心性肥胖、血糖增高、葡萄糖耐量减低、红细胞增多、白细胞计数及中性粒细胞增多、血钠升高、血钾和钙降低。
这些症状提示可能存在内分泌失调,特别是与肾上腺皮质功能相关的问题。
- 向心性肥胖:提示皮质醇分泌过多,这是肾上腺皮质功能亢进的典型表现之一。
- 血糖增高和葡萄糖耐量减低:表明存在糖代谢异常,这也是肾上腺皮质激素过多导致的常见现象。
- 血钠升高、血钾和钙降低:这是肾上腺皮质激素分泌过多时常见的电解质紊乱表现。
综上所述,这些症状和实验室结果最符合肾上腺皮质功能亢进这一诊断。
因此,正确的选择是C:肾上腺皮质功能亢进。
57、肾单位不包括
A、肾小球B、肾小囊
C、肾小管
D、集合管
E、髓袢
【答案】D
【解析】集合管并非肾单位的一部分。
肾单位包括肾小球、肾小囊、近曲小管、髓袢和远曲小管。
58、某患者,查体发现血清抗-HIV阳性,护士对其进行健康教育指导时,不正确的是
A、排泄物用漂白粉消毒B、严禁献血
C、性生活应使用避孕套
D、不能和他人共用牙刷
E、外出时应戴口罩
【答案】E
【解析】外出时应戴口罩这一选项(E)在针对HIV感染者进行健康教育指导时不正确,因为HIV主要通过性接触传播、血液传播以及母婴垂直传播,而戴口罩对预防这些传播方式并无直接影响。
正确的健康教育应重点放在避免上述传播途径上,如使用安全套、不共享针具、避免不安全性行为等。
因此,对于HIV感染者而言,外出是否戴口罩并不是健康教育中的关键指导内容。
59、CH50试验方法又称为
A、补体5%溶血试验B、抗体5%溶血试验
C、补体50%溶血试验
D、抗体50%溶血试验
E、补体100%溶血试验
【答案】C
【解析】CH50试验方法被称为补体50%溶血试验(C:补体50%溶血试验)。
这一试验通过监测50%溶血点来评价补体系统的整体活性。
60、胸腔积液中乳酸脱氢酶活性最高的疾病是
A、结核性胸膜炎B、化脓性胸膜炎
C、癌性胸腔积液
D、心力衰竭
E、肝硬化
【答案】B
【解析】化脓性胸膜炎是导致胸腔积液中乳酸脱氢酶(LDH)活性升高的主要原因。
这是因为化脓性胸膜炎时,炎症反应强烈,伴随有大量白细胞浸润,包括巨噬细胞、中性粒细胞等,这些细胞在代谢过程中会产生大量乳酸,进而释放出高浓度的LDH进入胸腔积液中。
因此,在胸腔积液的检查中,若发现LDH水平显著升高,特别是与血清LDH比值明显增高,提示可能存在化脓性胸膜炎的可能性。
其他选项解析如下:
- A: 结核性胸膜炎:虽然也会引起胸腔积液,但其LDH活性通常不会显著高于化脓性胸膜炎。
- C: 癌性胸腔积液:LDH活性可能也较高,但通常不如化脓性胸膜炎显著。
- D: 心力衰竭:可能导致胸腔积液,但LDH升高的原因主要是心肌损伤而非炎症反应。
- E: 肝硬化:可导致腹水而非胸腔积液,且LDH升高的主要原因是肝脏疾病本身。
综上所述,化脓性胸膜炎是胸腔积液中乳酸脱氢酶活性最高疾病的正确答案。
61、化学发光免疫分析常用的直接化学发光剂是
A、吖啶酯B、鲁米诺
C、AMPPD
D、二甲基噻吩衍生物及Eu3+螯合物
E、三联吡啶钌
【答案】A
【解析】直接化学发光免疫分析中常用的直接化学发光剂是吖啶酯(A)。
在化学发光免疫分析中所使用的标志物可分为两类,一类是直接用化学发光剂(如吖啶酯)标记抗原或抗体;另一类是用化学发光反应中的催化剂(如辣根过氧化物酶、碱性磷酸酶等)标记抗原或抗体。
(62~65为共用题干)
患者脑脊液标本送到化验室检测 。
。
 。
。62、如图所示检测到的细菌为
A、葡萄球菌B、链球菌
C、肺炎链球菌
D、大肠埃希菌
E、新型隐球菌
【答案】E
【解析】墨汁负染色:适用于隐球菌的检查。可见新型隐球菌具宽厚荚膜。
63、新型隐球菌检测常用的实验方法是
A、棉蓝染色法B、革兰染色法
C、镀银染色法
D、吉姆萨染色
E、墨汁染法
【答案】E
【解析】墨汁负染色:适用于隐球菌的检查。可见新型隐球菌具宽厚荚膜。因此符合题干的选E。
64、墨汁负染是利用新型隐球菌的哪种细胞结构特点来进行鉴定
A、芽孢B、荚膜
C、菌毛
D、单鞭毛
E、周鞭毛
【答案】B
【解析】墨汁负染色:适用于隐球菌的检查。可见新型隐球菌具宽厚荚膜。因此符合题干的选B。
65、新生隐球菌的主要传播方式是
A、病人-咯痰-飞沫传播B、鸽子-粪便-呼吸道传播
C、病人-粪便-消化道传播
D、病人-粪便-呼吸道传播
E、人虱-粪便-破损皮肤传播
【答案】B
【解析】新型隐球菌广泛分布于自然界,也可存在于人体体表、口腔和肠道中。其感染属外源性感染。可经呼吸道侵入人体,由血流播散至脑及脑膜,也可侵犯皮肤、骨和关节。因此B符合。
(66~68为共用题干)
患者女,26岁。外阴瘙痒伴分泌物增多2天,分泌物稀薄,实验室检查:阴道清洁度Ⅲ度,线索细胞阳性、加德纳菌(++)、杂菌(+)、白细胞(++),未检出霉菌和滴虫。
66、该患者可能的诊断是
A、滴虫性阴道炎B、细菌性阴道炎
C、淋病
D、真菌性阴道炎
E、阿米巴性阴道炎
【答案】B
【解析】细菌性阴道炎的临床诊断依据为:(1)线索细胞:为阴道鳞状上皮细胞黏附大量加德纳菌及其他短小杆菌后形成。(2)pH:>4.5。(3)胺试验:阳性。(4)阴道分泌物稀薄均匀。凡有线索细胞,再加上述任意其他2条,诊断即成立。
67、黄色泡沫样白带提示为
A、滴虫性阴道炎B、霉菌性阴道炎
C、老年性阴道炎
D、幼女性阴道炎
E、阿米巴阴道炎
【答案】A
【解析】黄色泡沫状脓性白带,常见于滴虫性阴道炎。
68、白带外观呈豆腐渣样,提示为
A、老年性阴道炎B、滴虫样阴道炎
C、念珠菌性阴道炎
D、宫颈息肉
E、子宫内膜炎
【答案】C
【解析】豆腐渣样白带:常见于真菌性阴道炎。
(69~70为共用题干)
患者,男性,10岁,关节腔出血。检查:PLT211×109/L,BT12min,PT13s(正常对照12s),APTT67s(对照32s)。
69、该患者检查结果异常的项目是
A、PLT、BTB、BT、PT
C、BT、APTT
D、PLT、PT
E、PLT、APTT
【答案】C
【解析】出血时间(BT)是测定皮肤在特定条件下损伤后,出血自然停止所需的时间即为出血时间;APTT是内源凝血系统较敏感和常用的筛选试验。该患者BT12min,明显时间延长,APTT67s(对照32s)异常,而PLT和PT正常。所以该患者检查结果异常的项目是BT、APTT。
70、该患者下一步应采取的检查是
A、肝功能检查B、肾功能检查
C、血常规检查
D、APTT纠正试验
E、骨髓穿刺
【答案】D
【解析】活化部分凝血酶时间测定(APTT)临床意义:对内源凝血途径因子(Ⅷ、Ⅸ、Ⅺ)缺乏较CT敏感(血小板异常不影响APTT),能检出Ⅷ∶C小于25%的轻型血友病。对凝血酶原、纤维蛋白原缺乏则不够敏感,故APTT延长的最常见疾病为血友病。此时可进一步做纠正试验,即于患者血浆中加入1/4量的正常新鲜血浆、硫酸钡吸附血浆或正常血清,再检测APTT。如正常血浆和吸附血浆能纠正延长的结果而血清不能纠正,则为因子Ⅷ缺乏;如吸附血浆不能纠正,其余两者都能纠正,则为因子Ⅸ缺乏;如三者都不能纠正,则为病理性循环抗凝物质。该患者BT、APTT凝血时间延长,所以最符合该患者下一步应采取的检查是APTT纠正试验。
(71~73为共用题干)
患者,女,48岁。近一年来体重减轻,多食易饥,怕热多汗,心悸,易怒,体检:消瘦,双侧甲状腺肿大,心率110次/分。
71、该患者最可能的诊断是
A、慢性肾炎B、糖尿病
C、艾迪生病
D、甲亢
E、甲减
【答案】D
【解析】由于甲状腺激素分泌过多出现的症状与物质代谢增强、氧化加速、散热增多有关。患者有乏力、怕热、多汗、体重锐减、心悸、气促、食欲亢进、紧张、焦虑、易怒等症状。该患者近一年来体重减轻,多食易饥,怕热多汗,心悸,易怒,体检:消瘦,双侧甲状腺肿大,最可能的诊断是甲亢。
72、为明确诊断及疾病严重程度最有意义的检查项目是
A、血清游离T3、T4B、血清总T3、T4
C、131I摄取试验
D、血皮质醇
E、甲状腺自身抗体
【答案】A
【解析】目前认为联合进行FT3、FT4和超敏TSH测定,是甲状腺功能评估的首选方案和第一线指标。
73、甲状腺功能改变时,下列较T3、T4反应更迅速的项目是
A、血清TSHB、血GH
C、血皮质醇
D、TRH兴奋实验
E、131I摄取实验
【答案】A
【解析】目前认为联合进行FT3、FT4和超敏TSH测定,是甲状腺功能评估的首选方案和第一线指标。
(74~78为共用题干)
患者女性,25岁。因面色苍白、头晕、乏力1年余,近1个月伴心慌就诊。结婚半年,月经初潮14岁,7天/27天,末次月经半月前。近2年月经量多,半年来更明显。贫血貌,皮肤黏膜无出血点,浅表淋巴结不大,巩膜不黄染,口唇苍白,舌乳头正常,心肺无异常,肝脾不大。化验:Hb64g/L,RBC3.0×1012/L,MCV70fl,MCH25pg,MCHC300g/L,WBC6.5×109/L,分类:中性分叶70%,淋巴27%,单核3%,PLT260×109/L,网织红细胞1.5%,尿蛋白(-),镜检(-),大便潜血(-),血清铁6.0μmol/L。
74、该患者的贫血程度为
A、轻度贫血B、中度贫血
C、重度贫血
D、极重度贫血
E、增生不良性贫血
【答案】B
【解析】确定贫血的严重程度:根据Hb浓度,成人贫血程度划为4级。轻度:Hb参考区间下限至91g/L,症状轻微;中度:Hb90~60g/L,体力劳动时心慌气短;重度:Hb60~31g/L,休息时感心慌气短;极重度:Hb≤30g/L,常合并贫血性心脏病。
75、该患者最可能的诊断为
A、缺铁性贫血B、铁粒幼细胞性贫血
C、巨幼细胞性贫血
D、再生障碍性贫血
E、海洋性贫血
【答案】A
【解析】缺铁性贫血的血象:血红蛋白、红细胞均减少,以血红蛋白减少更为明显。白细胞计数及分类一般正常。血小板计数一般正常。血清铁<8.95μmol/L。故选A。
76、为了进一步确诊,下列最有意义的检查是
A、骨髓铁染色B、铁代谢检查
C、卟啉代谢检查
D、骨髓细胞学检查
E、骨髓活体组织检查
【答案】A
【解析】结合患者病史和检查结果,首先考虑为缺铁性贫血,具体分析如下:
1.临床诊断依据:
①患者为青年女性,有长期月经量增多史(近 2 年月经量多,半年来加重),符合缺铁性贫血的常见病因(慢性失血)。
②实验室检查:Hb 64g/L(中度贫血),MCV 70fl(<80fl)、MCH 25pg(<27pg)、MCHC 300g/L(<320g/L),提示小细胞低色素性贫血;血清铁 6.0μmol/L(降低,正常参考值约 9-30μmol/L),进一步支持缺铁性贫血。
2.各检查的意义:
骨髓铁染色(A):是诊断缺铁性贫血的金标准。缺铁性贫血时,骨髓幼红细胞外的铁(细胞外铁)减少或消失,幼红细胞内的铁(细胞内铁)减少(铁粒幼细胞 < 15%),可直接反映体内铁储备情况,对确诊缺铁性贫血最有意义。
铁代谢检查(B):包括血清铁、总铁结合力、转铁蛋白饱和度等,可辅助判断缺铁状态,但不如骨髓铁染色直接和特异(如慢性炎症性贫血也可能出现血清铁降低)。
卟啉代谢检查(C):主要用于诊断卟啉病(一类血红素合成障碍疾病),与本例小细胞低色素性贫血无关。
骨髓细胞学检查(D):可观察骨髓增生情况及红细胞形态(如幼红细胞体积小、胞质少、染色偏蓝),但无法直接反映铁储备,需结合铁染色结果。
骨髓活体组织检查(E):多用于诊断骨髓增殖性疾病、骨髓纤维化等,对缺铁性贫血的诊断价值有限。
综上,骨髓铁染色是进一步确诊缺铁性贫血最有意义的检查,故答案为 A。
77、下列关于该患者的实验室检查结果,错误的是
A、骨髓铁染色:细胞内铁明显减少或缺如,细胞外铁阴性B、血清铁蛋白<12μg/L
C、红细胞原卟啉>0.9μmol/L
D、骨髓主要以红系增生为主,粒红比值降低
E、增生的红系细胞表现为“核幼质老”的核质发育不平衡改变
【答案】E
【解析】核质发育不平衡:核发育落后于胞质,即幼核老质;胞质发育落后于核,即老核幼质。可见于白血病、巨幼细胞贫血及缺铁性贫血等。根据现有患者的实验室检查结果,不能判断患者有“核幼质老”。
78、本病对症治疗后,下列哪项指标对观察疗效最好
A、血涂片观察红细胞形态B、红细胞数量增多
C、细胞内铁减少
D、网织红细胞升高
E、骨髓增生明显活跃
【答案】D
【解析】缺铁性贫血、巨幼细胞贫血患者治疗前,网织红细胞仅轻度增高(也可正常或减少),给予铁剂或维生素B12、叶酸治疗3~5d后,网织红细胞开始上升,7~10d达高峰,2周后网织红细胞逐渐下降至正常水平,表明治疗有效。
(79~81为共用题干)
男性,10岁,牙龈反复出血,皮肤易出现瘀斑月余。实验室检查:PLT200×109/L,BT10min(IVY法),APTT55s(对照35s),FⅧ:C15%,vWF:Ag10%,瑞斯托霉素辅因子活性1%,对瑞斯托霉素诱导的血小板无聚集,其父也有类似病史。
79、该病可诊断为
A、血友病AB、血管性血友病
C、慢性ITP
D、血小板无力症
E、过敏性紫癜
【答案】B
【解析】血管性血友病其1型主要是由于vWF量的合成减少所致,而vWF的多聚体的结构基本正常,本型患者为常染色体显性遗传。实验室检查:瑞斯托霉素辅因子活性降低,凝血因子Ⅷ减少,血小板中多聚体结构正常; 该患儿牙龈反复出血,皮肤易出现瘀斑月余。瑞斯托霉素辅因子活性1%,对瑞斯托霉素诱导的血小板无聚集,其父也有类似病史。所以该病可诊断为血管性血友病。
80、进一步的检查是
A、PTB、APTT
C、BT
D、复钙交叉实验
E、vWF抗原或结构检测
【答案】E
【解析】vWD是由于因子Ⅷ复合物中的血管性血友病因子(vWF)基因的合成与表达缺陷而导致它的质和量异常所引起的出血性疾病。所以进一步的检查是vWF抗原或结构检测。
81、该病的遗传方式是
A、常染色体隐性遗传B、常染色体不完全显性遗传
C、常染色体显性遗传
D、X染色体性连锁显性遗传
E、X染色体性连锁隐性遗传
【答案】C
【解析】血管性血友病1型:主要是由于vWF量的合成减少所致,而vWF的多聚体的结构基本正常,为常染色体显性遗传,实验室检查vHTF抗原减少,5%~30%左右,瑞斯托霉素度因子活性下降,血小板多聚体结构正常。该患儿牙龈反复出血,皮肤易出现瘀斑月余。实验室检查血小板减少,FⅧ:C15%,vWF:Ag10%,瑞斯托霉素辅因子活性1%,对瑞斯托霉素诱导的血小板无聚集,其父也有类似病史。符合血管性血友病1型表现,故本题选C。
(82~83为共用题干)
患者,男,50岁。身高170cm,体重75kg,正常体检抽血,标本离心后血清浑浊,静置过夜,上层呈乳白色,下层透明。
82、乳白色层的主要成分是
A、CMB、HDL
C、LDL
D、VLDL
E、IDL
【答案】A
【解析】精简重要解析:
当在正常体检中抽血并检测血清时,若发现血清静置过夜后上层乳白色、下层透明,则表明该样本中含有大量的CM(乳糜微粒)。
CM是脂蛋白的一种,主要负责运输外源性脂肪酸。
因此,正确答案为A: CM。
83、患者属于几型高脂血症
A、Ⅰ型高脂蛋白血症B、Ⅱ型高脂蛋白血症
C、Ⅲ型高脂蛋白血症
D、Ⅳ型高脂蛋白血症
E、Ⅴ型高脂蛋白血症
【答案】A
【解析】患者血清经离心后浑浊,静置过夜出现乳白色上层和透明下层,这特征符合Ⅰ型高脂蛋白血症的表现。
因此,正确答案是A:Ⅰ型高脂蛋白血症。
(84~85为共用题干)
患者,男,20岁。多食、多饮、多尿,体重减轻半年,恶心、呕吐、乏力5天,昏迷1天。血糖28.2mmol/L。
84、最可能的诊断是
A、肾功能损害B、肝硬化昏迷
C、乳酸酸中毒
D、酮症酸中毒
E、脑血管意外
【答案】D
【解析】糖尿病酮症酸中毒是由于胰岛素缺乏而引起的以高血糖、高酮血症和代谢性酸中毒为主要表现的临床综合征,是严重威胁病人生命的急性并发症之一。
85、为明确诊断,最需要的检查是
A、肝功能B、尿酮体
C、OGTT
D、胰岛素
E、HbAlc
【答案】B
【解析】糖尿病酮症酸中毒尿酮体呈强阳性。
(86~88为共用题干)
患儿男,10岁,10天前晨起双眼水肿,尿色发红,尿量逐渐减少,入院查体,生命体征正常,发育正常,重病容,精神差。化验尿常规显示镜下红细胞可见,尿中有病理性管型,尿蛋白+++。
86、最可能的诊断是
A、急性肾小球肾炎B、肾病综合征
C、肾小管间质性肾炎
D、肾出血
E、紫癜性肾病
【答案】A
【解析】急性肾小球肾炎大多数为急性链球菌感染1~3周后,因变态反应而引起双侧肾弥漫性的肾小球损害,临床表现为急性起病,以血尿、蛋白尿、高血压、水肿、肾小球滤过率降低为特点的肾小球疾病。
87、少尿是指24小时尿量少于
A、17mlB、100ml
C、400ml
D、500ml
E、800ml
【答案】C
【解析】少尿指24h尿量少于400ml,或每小时尿量持续小于17ml(儿童<0.8ml/kg)者为少尿。
88、可出现血尿的疾病不包括
A、肾肿瘤B、肾结石
C、肾结核
D、急性肾小球肾炎
E、单纯性肾病综合征
【答案】E
【解析】肾病综合征一般不出现血尿,有大量蛋白尿、低蛋白血症等。
(89~90为共用备选答案)
A、肾小球B、近曲小管
C、髓祥
D、化学法
E、远曲小管
F、集合管
89、具有选择性滤过作用功能的是
【答案】A【解析】选择性滤过作用主要发生在肾小球中,其特点是对血浆蛋白的通过具有选择性,相对分子量较大的蛋白质不易滤过,而相对分子量较小的蛋白质较易滤过。
因此,具有选择性滤过作用功能的是肾小球。
90、肾脏重吸收最重要的部位是
【答案】B【解析】近曲小管是肾脏重吸收功能的关键部位,几乎负责所有重要物质(如葡萄糖、氨基酸、维生素和微量蛋白质)的重吸收。
(91~92为共用题干)
患者男,43岁。2小时前心前区剧烈疼痛就诊,疑为急性心肌梗死。
91、临床化学心肌相关检查结果中最先出现阳性的检查是
A、MbB、CK
C、LDH
D、Tnl
E、AST
【答案】A
【解析】在疑似急性心肌梗死的诊断中,临床化学检测中Mb(肌红蛋白)是最先出现阳性的指标。
Mb分子量小,能快速从受损的心肌细胞释放进入血液,其升高速度快于其他心脏酶类,因此在AMI发病后1-3小时即可检测到浓度上升,有助于早期诊断。
92、确诊心梗最好的生化检查项目是
A、MYOB、CK
C、LDH
D、TnI
E、AST
【答案】D
【解析】确诊心肌梗死最好的生化检查项目是TnI(肌钙蛋白I)。
TnI在心肌损伤后较早释放入血,是评估急性心肌梗死的首选指标。






